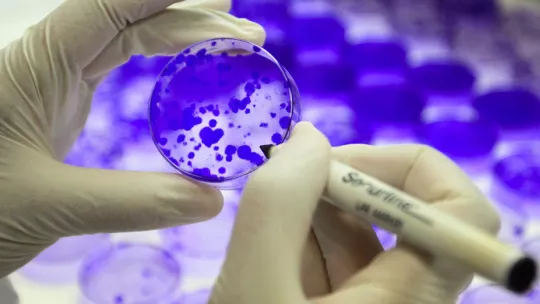

IRB Barcelona is offering up to 5 PhD fellowships for young scientists from the national and international community who wish to undertake a doctoral degree in biomedicine. We encourage applications from highly motivated graduates with outstanding qualifications in biology, chemistry, biochemistry, physics, pharmacology, computational biology or related fields. Successful candidates will join research groups headed by top-level scientists and will carry out their research in cutting-edge fields of biomedicine in a stimulating environment.
For this call the following grants will be offered:
-
Up to 5 fellowships associated with the “Contratos Predoctorales para la Formación de Doctores (FPI)” 2020 call assigned to the Severo Ochoa Accreditation funded by the “Ministerio de Ciencia, Innovación y Universidades (MICIU)”. (Herein referred to as Severo Ochoa Grants).
The Severo Ochoa Grants will be regulated by the MICIU call, following the conditions of this government agency.
IRB Barcelona is offering up to 5 PhD fellowships for young scientists from the national and international community who wish to undertake a doctoral degree in biomedicine. We encourage applications from highly motivated graduates with outstanding qualifications in biology, chemistry, biochemistry, physics, pharmacology, computational biology or related fields. Successful candidates will join research groups headed by top-level scientists and will carry out their research in cutting-edge fields of biomedicine in a stimulating environment.
For this call the following grants will be offered:
-
Up to 5 fellowships associated with the “Contratos Predoctorales para la Formación de Doctores (FPI)” 2020 call assigned to the Severo Ochoa Accreditation funded by the “Ministerio de Ciencia, Innovación y Universidades (MICIU)”. (Herein referred to as Severo Ochoa Grants).
The Severo Ochoa Grants will be regulated by the MICIU call, following the conditions of this government agency.
Check out IRB Barcelona groups participating in this frame:
- Angel Nebreda - Signalling and Cell Cycle Laboratory
- Antonio Zorzano - Complex Metabolic Diseases and Mitochondria
- Cayetano González - Cell Division Laboratory
- Fran Supek - Genome Data Science

- Francesc Posas - Laia de Nadal - Cell Signalling
- Jens Lüders - Microtubule Organization

- Lluis Ribas - Gene Translation Laboratory

- Manuel Palacin - Amino Acid Transporters and Disease
- Marco Milan - Development and Growth Control Laboratory

- Modesto Orozco - Molecular Modelling and Bioinformatics
- Nuria López-Bigas - Biomedical Genomics

- Patrick Aloy - Structural Bioinformatics and Network Biology

- Raúl Méndez - Translational Control of Cell Cycle and Differentiation
- Salvador Aznar-Benitah - Stem Cells and Cancer
- Toni Gabaldon - Comparative Genomics
- Toni Riera - Research Unit on Asymmetric Synthesis
- Xavier Salvatella - Laboratory of Molecular Biophysics


Eligibility
- The programme is aimed at students who have completed one of the following options:
- a) the studies that lead to an official Spanish (or from another country of the European Higher Education Area) university degree in Biology, Chemistry, Biochemistry, Pharmacy, Physics, Medicine, Chemistry or related fields and that have 300 credits (ECTS), of which at least 60 must correspond to master level.
- b) a degree in a non-Spanish university not adapted to the European Higher Education Area that gives access to doctoral studies in Biology, Chemistry, Biochemistry, Pharmacy, Physics, Medicine, Chemistry or related fields.
- Candidates are selected exclusively on merit, on the basis of their curricula. The academic grades and curriculum of each applicant are evaluated, as well as recommendation letters and a motivation letter. No selection criteria for positive or negative discrimination are applied.
How to apply
-
Applicants should complete and submit the online form. More information regarding the application can be found in the “Useful Information” tab.
Applicants will be asked to upload the following documents: *Please note that all the documents provided should be in PDF format.
- Curriculum vitae
- A motivation letter
- A scanned copy of the student’s certified Academic Record. These documents must show the grades attained in exam periods.
- Any additional files considered relevant to the application
- Two recommendation letters from university lecturers or scientists with who the applicant has studied or worked. Only letters with official letterhead and signature will be accepted.
Students will be required to provide a brief summary of work experience and to request letters of recommendation from two scientists who are familiar with their academic work and who can judge their potential as a PhD student. Candidates are responsible for ensuring that referees submit these letters. Applications not supported by these letters will not be eligible.
Please indicate the Research Node(s) to which you wish to apply (up to 3).
Research Nodes:
- Chemical and Structural Biology
- Cell Pathophysiology
- Computational Biology
- Invertebrate Models of Disease
- Preclinical Models of Cancer
- Preclinical Models of Disease
More information on the research activities of each group can be found on the IRB Barcelona webpage.
Applicants should submit information in English (CV, motivation letter, summary of work experience). If the certified academic records are not in Catalan, Spanish or English applicants should also attach a translation in one of the above mentioned languages.
For more information, please, contact phd@irbbarcelona.org
Selection procedure
Students are selected from a pool of highly qualified international applicants on the basis of academic and technical excellence.
Applications will be reviewed by a selection committee consisting of IRB Barcelona group leaders and members of the IRB Barcelona PhD Advisory Committee. Short-listed candidates will receive invitations for online interviews during 1-2 October 2020. Offers of admission will be made to the successful candidates shortly after the interview period. Students should expect to take up their positions at IRB Barcelona by April-May, 2021.
Applicants who have not been successful but who have received a positive evaluation will be put on a waiting list to cover possible renunciations and future positions.
Calendar
Call opening: 5 August 2020
Deadline for candidacies: 9 September 2020
Pre-selection of candidates: 23 September 2020
Interviews at IRB Barcelona: 1 & 2 October 2020
Notification to candidates: By mid of October 2020
Start date of fellowships: April - May 2021



